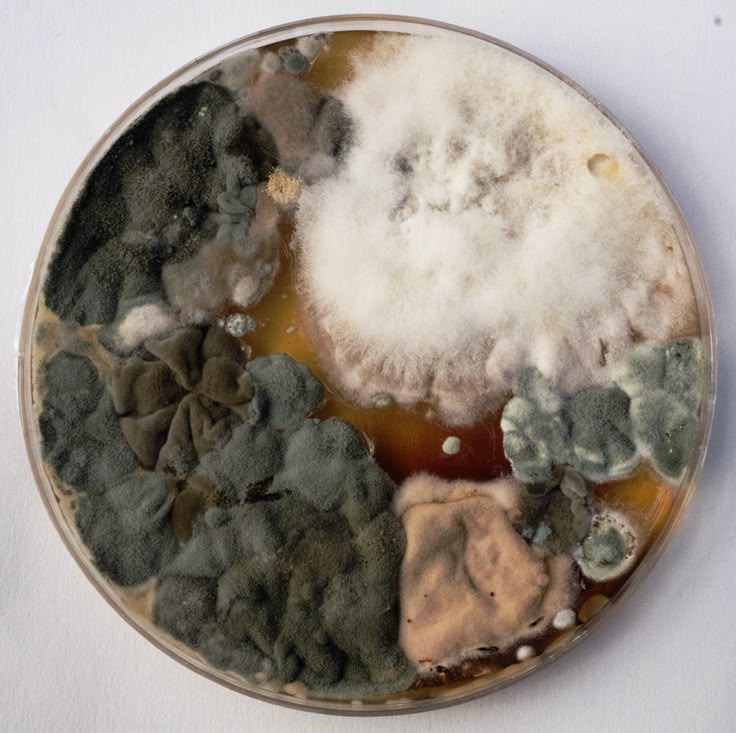

“눈에 보이지 않아도 위험하다” 세계 기준으로 본 우리 집 실내 환경
“곰팡이가 조금 피었는데, 이게 그렇게 위험한가요?”
욕실 실리콘 틈, 베란다 구석, 벽지 뒤에 살짝 핀 곰팡이.
대부분은 그냥 물티슈로 닦거나 락스로 살짝 지우고 넘기시죠.
하지만 곰팡이는 단순한 오염이 아니라
건강에 심각한 영향을 줄 수 있는 실내 유해 요인이라는 사실, 알고 계셨나요?
세계보건기구 WHO는 이를 더 이상 ‘단순한 불쾌감’이 아닌
“건강을 위협하는 생물학적 오염물질”로 분류하고 있습니다.
WHO는 실내 곰팡이에 대해 어떻게 말하고 있을까?
세계보건기구(WHO)는 2009년,
《WHO Guidelines for Indoor Air Quality: Dampness and Mould》라는 권고안을 통해
실내 곰팡이와 습기로 인한 건강 피해를 명확히 지적했습니다.
WHO 공식 입장 요약:
“실내 습기 및 곰팡이는 천식, 알레르기, 호흡기 질환과 직접적인 연관이 있으며,
노출을 피하는 것이 건강을 지키는 데 중요하다.”
즉, 곰팡이가 '얼마나 많냐'가 아니라 '존재하느냐' 자체가 문제인 겁니다.
WHO 가이드라인 핵심 요점 정리
1.실내에서 곰팡이 냄새 또는 얼룩이 감지되면 즉시 제거해야 함
냄새만 나는 상태도 '노출'로 간주
2.곰팡이 제거보다 더 중요한 것은 원인 제거
습기, 결로, 통풍 불량이 있으면 재발 확률 높음
3.알레르기, 천식, 면역력 저하자는 곰팡이에 더욱 취약
특히 어린이, 노인, 만성질환자는 매우 위험
4.곰팡이 수치 기준은 없지만, 인체에 무해한 최소 수준도 존재하지 않음
“실내 환경에서 곰팡이 노출은 가능한 한 ‘0’이어야 한다”
참고: WHO Indoor Air Quality Guidelines (2009), Chapter 3. “Health effects of dampness and mould”
국내 기준은? WHO와 얼마나 차이 날까?
대한민국의 경우 실내 공기질 기준에는
‘곰팡이 농도 수치’가 명확히 존재하지 않습니다.
다만, 일부 공동주택 시공 가이드라인과
학교 실내 공기질 관리 지침에서 곰팡이 지표를 참고하는 정도입니다.
[출처] 국립환경과학원, 주거환경 건강 가이드라인 (2020)
“실내 곰팡이 발생은 결로, 단열 불량 등 건축 구조 문제가 주요 원인이며,
장기적으로는 호흡기 질환 발생 가능성을 높인다.”
WHO는 곰팡이 농도 측정보다,
곰팡이 존재 여부 자체를 관리 대상으로 보며,
국내도 점차 이러한 방향으로 가이드를 바꾸고 있습니다.
우리 집은 안전할까? 이렇게 점검해보세요
곰팡이 점검 체크리스트:
1.벽지에 얼룩 or 부풀어 오른 곳이 있다
2.욕실 실리콘, 베란다 천장에 검은 얼룩이 있다
3.장롱 뒤편이 눅눅하거나 곰팡이 냄새가 난다
4.환기 잘 안 되고 결로 자주 생긴다
5.침대 매트리스에 습기 차는 느낌이 든다
하나라도 ‘예’라면,
당장 곰팡이 환경 진단이 필요합니다.
WHO 기준을 바탕으로 한 실제 대처법
1.습기 관리 = 곰팡이 예방의 핵심
제습기 사용, 장마철에는 환기보다 제습 중심
가구는 벽과 5cm 이상 띄우기
결로 방지 단열 시공 고려
2.곰팡이 발생 시 락스는 임시방편일 뿐
곰팡이균의 뿌리는 벽 내부까지 퍼져 있음
물리적 제거와 함께 전문 시공이 필요한 경우가 많음
3.WHO처럼 ‘존재 자체’를 기준으로 생각해야 함
“조금밖에 안 보이니까 괜찮다”는 착각에서 벗어나야 함
곰팡이는 냄새, 눈에 안 보이는 포자 형태로 더 위험할 수 있음
WHO 권고가 중요한 이유는 단 하나 - 건강
아이의 비염과 천식이 반복된다면?
자꾸만 기침이 나고, 코가 막히고, 가려운 피부로 괴롭다면?
원인은 밖이 아니라
‘우리 집 안 공기’일 수도 있습니다.
곰팡이는
“피부 접촉”
“공기 흡입”
“알레르기 반응”
을 통해 몸속에 영향을 주고,
심할 경우 만성 기관지염, 폐질환까지 유발할 수 있다는 연구도 있습니다.
참고: EPA & WHO 공동 연구, "Indoor mould and respiratory outcomes" (2019)
곰팡이, 보는 것보다 기준이 먼저입니다
곰팡이를 ‘냄새’나 ‘얼룩’으로만 판단하던 시대는 지났습니다.
이제는 WHO처럼,
곰팡이 유무 자체로 실내 안전성을 판단해야 할 때입니다.
우리 가족이 하루의 80% 이상을 보내는 실내 공간.
그 환경이 ‘숨 쉴 수 없는 공간’이 되지 않도록
곰팡이 제거, 단열 시공, 제습 설계 등
지금부터 하나씩 실천해보세요.
다음 포스팅은 곰팡이와 건축 단열 미비가 부른 구조적 문제에
대해서 글을 준비해 드리겠습니다:)
'곰팡이' 카테고리의 다른 글
| 곰팡이 피해 보상 성공 사례 3가지 (0) | 2025.07.09 |
|---|---|
| 곰팡이 피해 보상 가능할까? (0) | 2025.07.09 |
| 곰팡이 제거 업체 시공 시 주의사항 (0) | 2025.07.08 |
| 곰팡이와 건축 단열 미비가 부른 구조적 문제 (1) | 2025.07.08 |
| 곰팡이와 아토피, 무관하지 않습니다 (0) | 2025.07.06 |
| 곰팡이 피부염과 무좀, 같은 곰팡이지만 전혀 다른 질병입니다 (0) | 2025.07.05 |
| 곰팡이와 피부 트러블, 말라세지아 모낭염이란? (0) | 2025.07.04 |
| 곰팡이 제거 후에도 냄새가 계속 나는 이유! (0) | 2025.07.03 |



